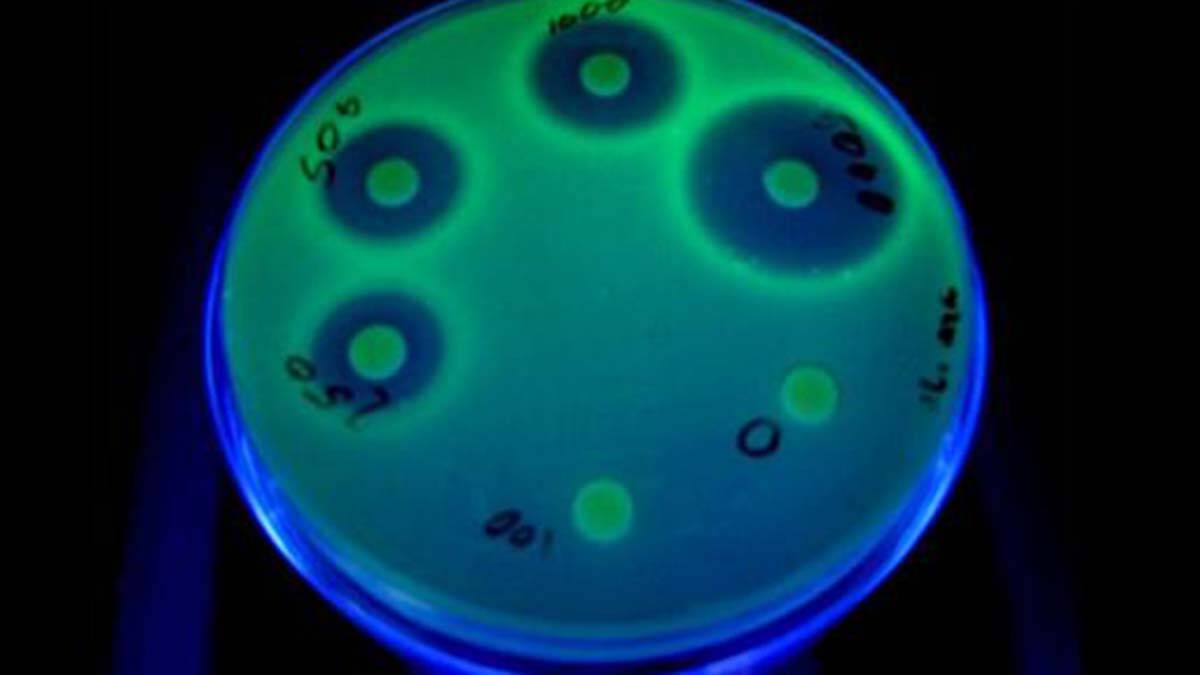

İsrail İbrani Üniversitesi’nden Bilim İnsanları Kara Mayınını Uzaktan Tespit Edecek Sistem Geliştirdiğini Duyurdu
İsrail İbrani Üniversitesi’nden bilim insanı Prof Shimshon Belkin ve ekibi, yaklaşık 10 yıldır üzerinde çalıştıkları kara mayınını uzaktan tespit edecek ‘ışıldayan koli basili’ bilimsel çalışmasında 3 yıl içinde geniş alan testlerine başlanacağını açıkladı. Çalışma hakkında açıklama yapan Prof. Belkin, hedeflerinin genetiği değiştirilen koli basili bakterisinin, mayın olduğu şüphelenilen bölgeye serpilmesiyle, ateşböceği gibi parlaması ve mayının yerini uzaktan tespit edilmesi olduğunu söyledi.
Kara mayınlarının güvenli ve kolaylıkla temizlenmesi konusunda yaklaşık 10 yıldır biyo-teknolojik bilimsel çalışma yapan Prof. Shimshon Belkin ve ekibi, geliştirdikleri yöntem hakkında DHA’ya özel açıklamalarda bulundu. Prof. Belkin, denizlerde ışıldayan bakterilerdeki (Biyolüminesans) geni alarak koli basiliye klonladıklarını ve bu bakterileri kara mayını üzerine serpildiğinde ışık üretecek şekilde dizayn ettiklerini belirtti.
Bilimsel çalışmanın 3 yıl içinde geniş ölçekte testlerine başlayacaklarını belirten Prof. Belkin “Bizim yaptığımız ana değişiklik, denizde ışıldayan bakteriden gelen ışıldama genlerini koli basiliye klonlamaktı. Klonlama, hedef moleküllerin (bizim çalışmamızda patlayıcı TNT veya DNT) varlığına reaksiyon vererek bu genleri aktive edecek ve ışık üretimine neden olacak şekilde yapıldı. Ek olarak, reaksiyonun daha hızlı, daha güçlü ve daha hassas olmasına yardımcı olan birkaç ek moleküler manipülasyon ekledik. Yani patlayıcıların daha düşük konsantrasyonlarını tespit etmek için” ifadelerini kullandı.
“Çevre ve İnsan Sağlığı için Risk Oluşturmuyor”
Genetik değişikliğe uğratılan koli basili bakterisinin toprağa veya insana ne yararlı ne de zararlı olmadığını vurgulayan Prof. Belkin, “Çevre ve insan sağlığı için risk oluşturmadığını belirterek “Kara mayınları tamamen kapatılamıyor ve patlayıcı buharlarının izleri, böylece madenin gövdesinden çıkıyor ve üzerindeki toprakta birikiyor. Köpeklerin veya farelerin gömülü mayınları algılamak için eğitilmiş olmalarının nedeni budur. (Bu hayvanlar) Mayının kokusunu değil, üzerindeki iz patlayıcı moleküllerin kokusunu alır” ifadelerini kullandı. Prof. Belkin, bilimsel çalışmasının genetiği değiştirilmiş koli basilileri mayın tarlası olduğu şüphe duyulan bölgeye yayıp, birkaç saat sonra havadan fotoğraflama yaparak parlak noktaların mayın olduğunu tespit etmek amacını taşıdığını ifade etti.












